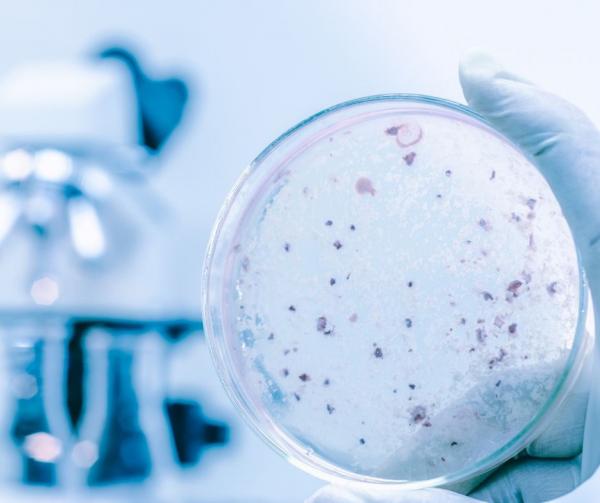
Si può misurare il Pulito?

Gestisci le tue preferenze
I cookie sono piccoli file di testo che vengono utilizzati per recuperare informazioni. Per garantire la privacy, da questo pannello è possibile esprimere le proprie preferenze per ogni tipologia di cookie che adottiamo.
-
Cookie Tecnici
Sono informazioni strettamente necessarie utilizzate per il corretto funzionamento del sito web. Ad esempio, utilizziamo un cookie tecnico per salvare le preferenze sui cookie da utilizzare.
-
Cookie Analitici
Vengono utilizzati per raccogliere informazioni ed effettuare delle statistiche. Questi dati ci permettono di capire come i visitatori interagiscono con il sito e questo ci permette di migliorare la navigazione e le performance.